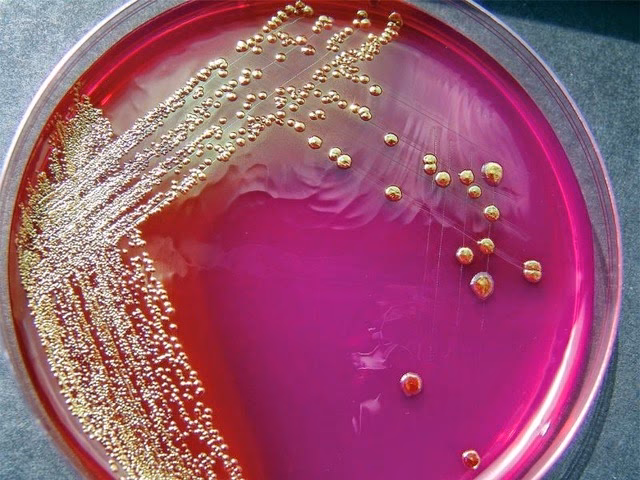

03/10/2002
En el vasto e invisible universo que nos rodea, cada gota de agua, cada gramo de tierra y hasta el aire que respiramos está repleto de una diversidad asombrosa de microorganismos. Bacterias, levaduras, hongos y otros seres diminutos coexisten en comunidades complejas, formando lo que conocemos como cultivos mixtos. Sin embargo, para poder entender el rol específico de cada uno de estos actores, para estudiar sus características, su metabolismo o su potencial, los científicos necesitan separarlos del resto. Aquí es donde entra en juego un concepto fundamental en la microbiología y la ecología: el cultivo puro. Este no es más que una población de microorganismos en un laboratorio que desciende de una única célula, garantizando que todos los individuos son genéticamente idénticos.

¿Qué es Exactamente un Cultivo Puro y por qué es Tan Importante?
Imagina un bosque lleno de cientos de especies de árboles, plantas y animales. Estudiar el comportamiento de una sola especie de ardilla en ese entorno tan complejo sería muy difícil. Un cultivo puro es el equivalente a llevar a esa ardilla a un entorno controlado donde solo hay individuos de su misma especie. En microbiología, un aislamiento exitoso nos proporciona una colección de microorganismos que contiene un solo tipo de especie. Esto se logra separando células individuales de una muestra mixta y permitiendo que cada una crezca de forma aislada.
El pilar de este proceso es la formación de una colonia. Cuando una única célula microbiana (como una bacteria o una levadura) se deposita en la superficie de un medio de cultivo sólido y nutritivo (como el agar), esta comienza a reproducirse. Al estar inmovilizada, todas sus descendientes se apilan en el mismo punto, formando una masa visible a simple vista. Esta masa, o colonia, es en esencia un clon de la célula madre original. Cada colonia que veamos en una placa de cultivo, si el aislamiento fue exitoso, representa un cultivo puro en miniatura.
La importancia de obtener estos cultivos es transversal a muchísimas áreas:
- Medicina: Para identificar el agente causante de una enfermedad infecciosa y determinar qué antibiótico es más efectivo contra él.
- Industria Alimentaria: Para producir fermentos como el yogur, el queso o la cerveza, se necesitan cepas puras de bacterias o levaduras específicas.
- Biotecnología: Para producir medicamentos (como la insulina), enzimas o biocombustibles, se utilizan cultivos puros de microorganismos modificados genéticamente.
- Ecología y Medio Ambiente: Para estudiar microorganismos capaces de degradar contaminantes (biorremediación), fijar nitrógeno en el suelo para mejorar la agricultura, o para analizar la calidad del agua.
Técnicas Maestras para el Aislamiento Microbiano
El objetivo principal del aislamiento es diluir la muestra original hasta el punto en que las células individuales queden tan separadas unas de otras que puedan formar colonias distintas y no superpuestas. Existen varias técnicas para lograr esto, siendo las más comunes la siembra por estría y las diluciones en serie.
Siembra por Estría o Agotamiento
Esta es la técnica más habitual y visualmente representativa en los laboratorios de microbiología. Su fundamento es una dilución mecánica sobre la superficie de una placa de agar.
- Se toma una pequeña cantidad de la muestra mixta con un asa de siembra esterilizada.
- Se realiza un primer trazo o estría en un cuadrante de la placa.
- Se esteriliza el asa de nuevo (generalmente con fuego) para eliminar el exceso de microorganismos.
- Se gira la placa y se realiza un segundo conjunto de estrías, arrastrando algunas células desde el final del primer cuadrante.
- Este proceso se repite para un tercer y a veces un cuarto cuadrante.
Con cada paso, se deposita un número menor de células. En las últimas estrías, las bacterias estarán lo suficientemente separadas como para que, tras la incubación, crezcan colonias aisladas. Cada una de estas colonias puede ser transferida a un nuevo medio estéril para obtener un cultivo puro a gran escala.
Banco de Diluciones en Serie
Esta técnica no solo permite aislar colonias, sino también estimar la cantidad de microorganismos presentes en la muestra original. Es un método cuantitativo.
- Se prepara una serie de tubos con un volumen conocido de líquido estéril (por ejemplo, 9 ml).
- Se añade un volumen conocido de la muestra original al primer tubo (por ejemplo, 1 ml), creando una dilución 1:10.
- Se mezcla bien y se transfiere 1 ml de esta primera dilución al segundo tubo, creando una dilución 1:100.
- El proceso se repite sucesivamente, obteniendo diluciones 1:1000, 1:10000, y así sucesivamente.
- Finalmente, se toma una pequeña cantidad de las diluciones más altas y se esparce uniformemente sobre la superficie de una placa de agar.
Tras la incubación, las placas sembradas a partir de las diluciones más altas tendrán un número reducido de colonias, perfectamente separadas y fáciles de contar y aislar.
Tabla Comparativa de Técnicas de Aislamiento
| Característica | Siembra por Estría / Agotamiento | Diluciones en Serie |
|---|---|---|
| Objetivo Principal | Aislamiento cualitativo de colonias. | Aislamiento y recuento cuantitativo. |
| Naturaleza del Método | Mecánica, por arrastre sobre superficie. | Matemática, por dilución en líquido. |
| Cuantificación | No es precisa para contar microorganismos. | Permite calcular las Unidades Formadoras de Colonias (UFC) por ml/g. |
| Material Requerido | Mínimo (asa de siembra, placas). | Más material (pipetas, varios tubos, placas). |
El Escudo Invisible: La Técnica Aséptica como Guardián del Cultivo
Obtener un cultivo puro es un trabajo delicado que puede ser arruinado en un instante por un enemigo invisible: la contaminación. Los microorganismos están por todas partes: en el aire, en nuestra piel, en las superficies del laboratorio. Para evitar que estos intrusos indeseados invadan nuestro cultivo, es imprescindible la técnica aséptica. Este conjunto de prácticas busca crear una barrera estéril entre el cultivo y el ambiente.
Algunos de los pilares de la técnica aséptica son:
- Esterilización: Todo el material (placas de Petri, tubos, pipetas) y los medios de cultivo deben ser esterilizados previamente, generalmente mediante calor en un autoclave, para eliminar cualquier forma de vida.
- Trabajo en un ambiente controlado: Se suele trabajar cerca de la llama de un mechero Bunsen, que crea una corriente de aire caliente ascendente que aleja los microbios del aire. Las cabinas de flujo laminar son aún más efectivas.
- Minimizar la exposición: Las placas y tubos se abren solo lo estrictamente necesario y se mantienen en ángulo para evitar que caigan partículas del aire en su interior.
- Esterilización de herramientas: Las asas de siembra se esterilizan al rojo vivo en la llama antes y después de cada uso.
Sin una rigurosa técnica aséptica, es imposible garantizar la pureza de un cultivo, y los resultados de cualquier experimento serían poco fiables.
Preguntas Frecuentes (FAQ)
P: ¿Se pueden aislar todos los microorganismos de una muestra?
R: No. Una de las grandes limitaciones de estas técnicas es que solo funcionan para microorganismos cultivables, es decir, aquellos que pueden crecer en las condiciones de laboratorio que les proporcionamos. Se estima que más del 99% de los microorganismos presentes en la naturaleza no pueden ser cultivados con los métodos actuales, lo que se conoce como "la gran materia oscura microbiana".
P: ¿Por qué la temperatura de incubación es importante?
R: Cada microorganismo tiene un rango de temperatura óptimo para su crecimiento. Al incubar las placas a una temperatura específica (por ejemplo, 37°C para bacterias del cuerpo humano o 25°C para hongos ambientales), favorecemos el desarrollo de los organismos que nos interesan y podemos observar cómo la temperatura influye en su velocidad de crecimiento y apariencia.
P: Si veo varias colonias de diferente color y forma en mi placa, ¿qué significa?
R: Significa que tu muestra original era un cultivo mixto y que tu técnica de aislamiento ha sido exitosa al separar los diferentes tipos de microorganismos. Cada tipo de colonia (distinguible por su color, tamaño, forma, textura) representa, muy probablemente, una especie diferente.
P: ¿Un cultivo puro dura para siempre?
R: No indefinidamente en el mismo medio. Los nutrientes se agotan y se acumulan productos de desecho tóxicos. Los cultivos puros deben ser transferidos a un medio fresco periódicamente (resiembra) o conservados a largo plazo mediante técnicas como la congelación a muy bajas temperaturas (-80°C) o la liofilización.
En conclusión, el cultivo puro es mucho más que una simple técnica de laboratorio; es la puerta de entrada para comprender el funcionamiento de los seres vivos más pequeños y abundantes del planeta. Desde curar enfermedades hasta limpiar la contaminación, la capacidad de aislar y estudiar una única especie microbiana es una de las herramientas más poderosas de la biología moderna, permitiéndonos descifrar los secretos de un mundo invisible que sustenta la vida en la Tierra.
Si quieres conocer otros artículos parecidos a Cultivo Puro: La Clave Para Estudiar Microorganismos puedes visitar la categoría Ecología.
